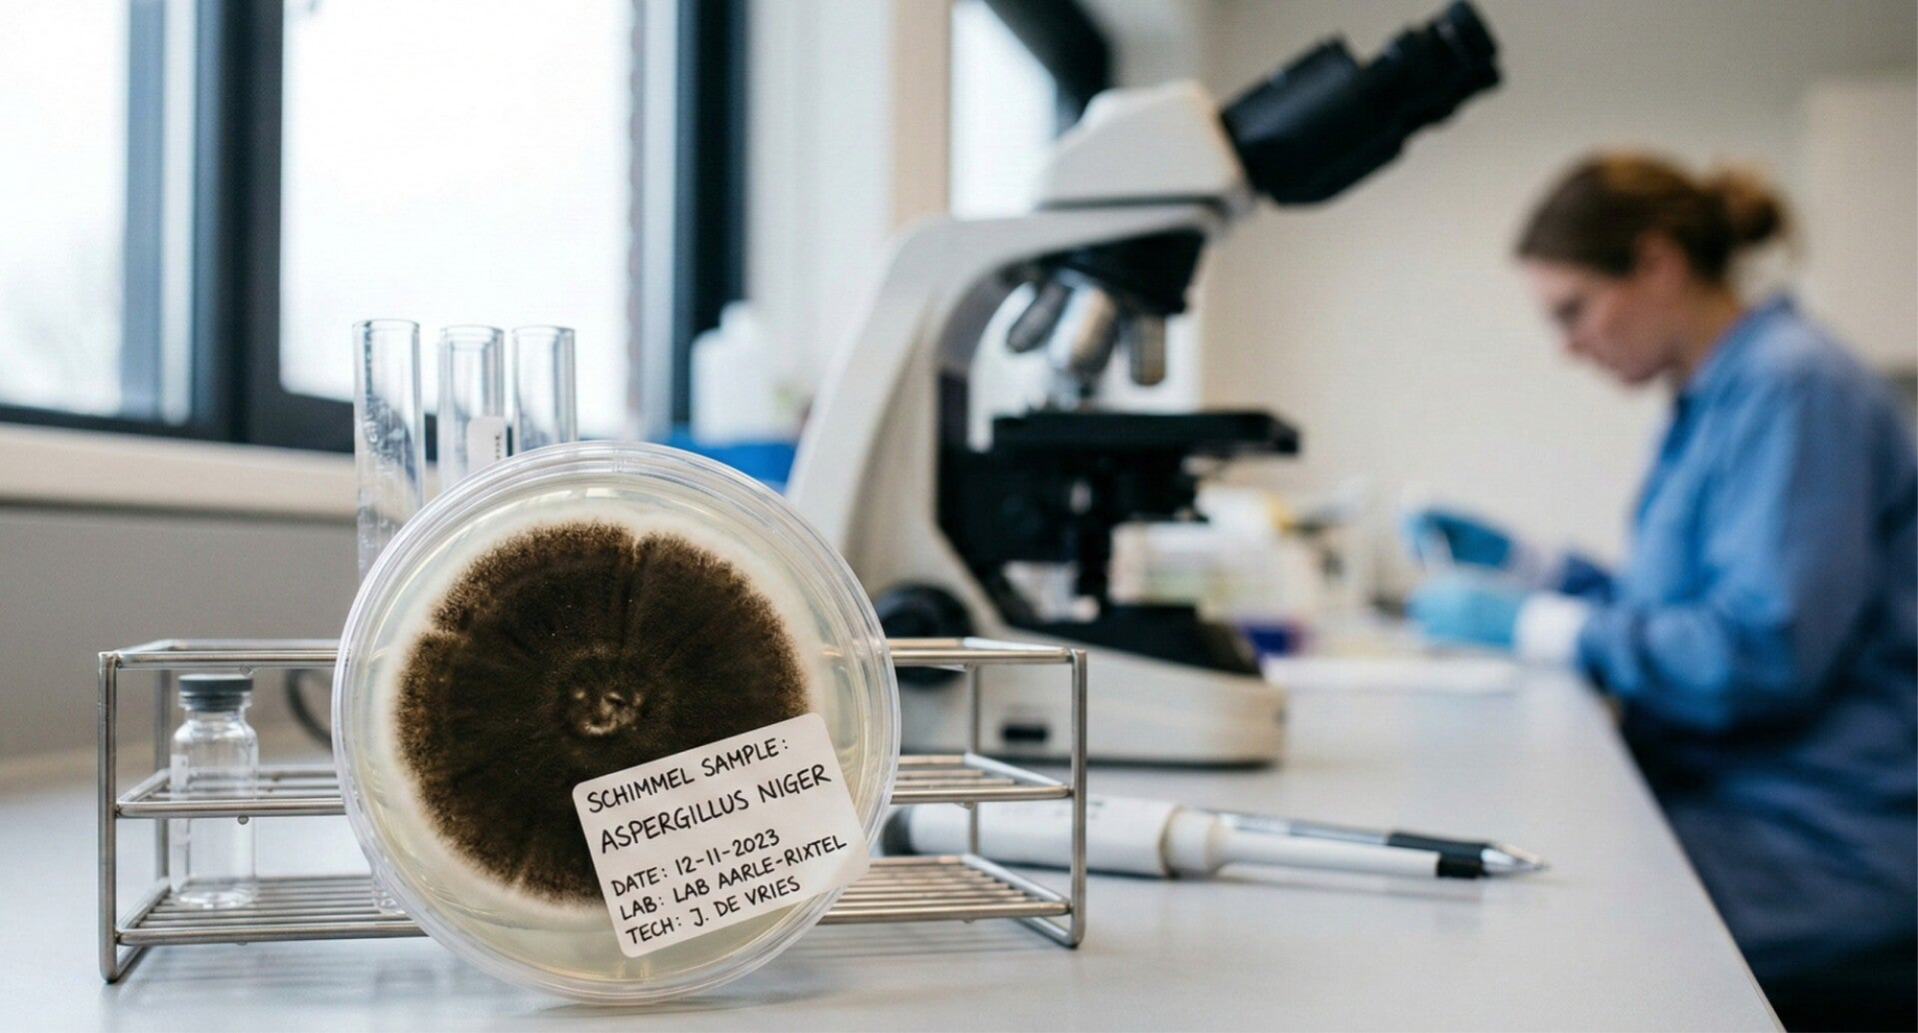
Sample afname schimmel

Diensten
We bieden een scala aan gespecialiseerde diensten die zijn afgestemd op jouw individuele behoeften. Onze aanpak is gericht op het begrijpen van en reageren op wat jij nodig hebt, en het bieden van effectieve en praktische oplossingen.
Inspectie en Analyse
Inspectie en analyse zijn cruciale stappen in verschillende sectoren, zoals de bouw, gezondheidszorg en productie. Tijdens een inspectie wordt zorgvuldig gekeken naar processen, producten of systemen om eventuele gebreken of afwijkingen te identificeren. Indien nodig worden aanpassingen of verbeteringen aanbevolen. Analyse gaat een stap verder en omvat het grondig onderzoeken van de gegevens die zijn verzameld tijdens de inspectie. Door de gegevens te interpreteren, kunnen patronen en trends onthuld worden. Dit biedt waardevolle inzichten die organisaties helpen bij het nemen van weloverwogen beslissingen. Het regelmatig uitvoeren van inspecties en analyses draagt bij aan kwaliteitsverbetering, risicobeheer en het waarborgen van de veiligheid. Kortom, beide elementen zijn onmisbaar voor een succesvolle werking en continue verbetering binnen een organisatie.
Wat we doen
We bieden een scala aan gespecialiseerde diensten die zijn afgestemd op jouw individuele behoeften. Onze aanpak is gericht op het begrijpen van en reageren op wat jij nodig hebt, en het bieden van effectieve en praktische oplossingen.